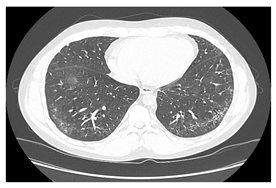

A Practical Multidisciplinary Approach to Identifying Interstitial Lung Disease in Systemic Autoimmune Rheumatic Diseases: A Clinician’s Narrative Review
Abstract
1. Introduction
2. Diagnostic Tools
2.1. Clinical Examination
2.2. Serological Testing
2.3. Imaging Examination
2.4. Pulmonary Function Tests
2.5. Pathological Exam
2.6. Bronchoalveolar Lavage
2.7. Serum Markers
2.8. Multidisciplinary Team
3. Early Diagnosis SARD-ILD
3.1. Early Diagnosis of SSc-ILD
3.2. Early Detection of MCTD-ILD
3.3. Early Detection of IIM-ILD
3.4. Screening for ILD in Patients with SjS
3.5. Early Detection of RA-ILD
3.6. Early Detection of SLE-ILD
4. Monitoring SARD-ILD Patients
4.1. Predictive Factors for SARD-ILD Progressive Fibrosing Phenotype
4.2. Monitoring SSc-ILD Patients for PPF Diagnosis
4.3. Monitoring MCTD-ILD Patients for PPF Diagnosis
4.4. Monitoring IIM-ILD Patients for PPF Diagnosis
4.5. Monitoring SjS-ILD for PPF Diagnosis
4.6. Monitoring RA-ILD Patients for PPF Diagnosis
4.7. Monitoring of SLE-ILD Patients for PPF Diagnosis
5. Conclusions
Author Contributions
Funding
Institutional Review Board Statement
Informed Consent Statement
Data Availability Statement
Conflicts of Interest
References
- Panagopoulos, P.; Goules, A.; Hoffmann-Vold, A.M.; Matteson, E.L.; Tzioufas, A. Natural history and screening of interstitial lung disease in systemic autoimmune rheumatic disorders. Ther. Adv. Musculoskelet. Dis. 2021, 13, 1759720X211037519. [Google Scholar] [CrossRef]
- Joy, G.M.; Arbiv, O.A.; Wong, C.K.; Lok, S.D.; Adderley, N.A.; Dobosz, K.M.; Johannson, K.A.; Ryerson, C.J. Prevalence, imaging patterns and risk factors of interstitial lung disease in connective tissue disease: A systematic review and meta-analysis. Eur. Respir. Rev. 2023, 32, 220210. [Google Scholar] [CrossRef]
- Sanduzzi Zamparelli, S.; Sanduzzi Zamparelli, A.; Bocchino, M. The Evolving Concept of the Multidisciplinary Approach in the Diagnosis and Management of Interstitial Lung Diseases. Diagnostics 2023, 13, 2437. [Google Scholar] [CrossRef]
- Storrer, K.M.; Müller, C.S.; Pessoa, M.C.A.; Pereira, C.A.C. Connective tissue disease-associated interstitial lung disease. J. Bras. Pneumol. 2024, 50, e20230132. [Google Scholar] [CrossRef]
- Koslow, M.; Maleki-Fischbach, M.; Keith, R.C. Diagnosis and Management of Interstitial Lung Disease in Patients with Connective Tissue Diseases. Case Rep. Rheumatol. 2021, 2021, 6677353. [Google Scholar] [CrossRef]
- Jokerst, C.; Yaddanapudi, K.; Chaudhary, S.; Zamora, A.C.; Nagaraja, V. Imaging Innovations in the Screening, Diagnosis, and Monitoring of Systemic Autoimmune Disease-Related Interstitial Lung Disease. EMJ Radiol. 2024, 5, 71–81. [Google Scholar] [CrossRef]
- Bernstein, E.J.; Jaafar, S.; Assassi, S.; Domsic, R.T.; Frech, T.M.; Gordon, J.K.; Broderick, R.J.; Hant, F.N.; Hinchcliff, M.E.; Shah, A.A.; et al. Performance Characteristics of Pulmonary Function Tests for the Detection of Interstitial Lung Disease in Adults With Early Diffuse Cutaneous Systemic Sclerosis. Arthritis Rheumatol. 2020, 72, 1892–1896. [Google Scholar] [CrossRef]
- Shao, T.; Shi, X.; Yang, S.; Zhang, W.; Li, X.; Shu, J.; Alqalyoobi, S.; Zeki, A.A.; Leung, P.S.; Shuai, Z. Interstitial Lung Disease in Connective Tissue Disease: A Common Lesion With Heterogeneous Mechanisms and Treatment Considerations. Front. Immunol. 2021, 12, 684699. [Google Scholar] [CrossRef]
- Tirelli, C.; Morandi, V.; Valentini, A.; La Carrubba, C.; Dore, R.; Zanframundo, G.; Morbini, P.; Grignaschi, S.; Franconeri, A.; Oggionni, T.; et al. Multidisciplinary Approach in the Early Detection of Undiagnosed Connective Tissue Diseases in Patients With Interstitial Lung Disease: A Retrospective Cohort Study. Front. Med. 2020, 7, 11. [Google Scholar] [CrossRef]
- Raghu, G.; Remy-Jardin, M.; Myers, J.L.; Richeldi, L.; Ryerson, C.J.; Lederer, D.J.; Behr, J.; Cottin, V.; Danoff, S.K.; Morell, F.; et al. American Thoracic Society, European Respiratory Society, Japanese Respiratory Society, and Latin American Thoracic Society. Diagnosis of Idiopathic Pulmonary Fibrosis. An Official ATS/ERS/JRS/ALAT Clinical Practice Guideline. Am. J. Respir. Crit. Care Med. 2018, 198, e68. [Google Scholar] [CrossRef]
- Althobiani, M.A.; Russell, A.M.; Jacob, J.; Ranjan, Y.; Folarin, A.A.; Hurst, J.R.; Porter, J.C. Interstitial lung disease: A review of classification, etiology, epidemiology, clinical diagnosis, pharmacological and non-pharmacological treatment. Front. Med. 2024, 11, 1296890. [Google Scholar] [CrossRef]
- Vancheri, C.; Basile, A. Multidisciplinary Approach to Interstitial Lung Diseases: Nothing Is Better than All of Us Together. Diagnostics 2020, 10, 488. [Google Scholar] [CrossRef]
- Namas, R.; Elarabi, M.; Fayad, F.; Muhanna Ghanem, A.A.; Al-Herz, A.; Hafiz, W.; Joshi, A.; Merashli, M.; Okais, J.; Uthman, I.; et al. Expert Opinion Guidance on the Detection of Early Connective Tissue Diseases in Interstitial Lung Disease. Open Access Rheumatol. 2023, 15, 93–102. [Google Scholar] [CrossRef]
- Ahmed, S.; Handa, R. Management of Connective Tissue Disease-related Interstitial Lung Disease. Curr. Pulmonol. Rep. 2022, 11, 86–98. [Google Scholar] [CrossRef]
- Jee, A.S.; Sheehy, R.; Hopkins, P.; Corte, T.J.; Grainge, C.; Troy, L.K.; Symons, K.; Spencer, L.M.; Reynolds, P.N.; Chapman, S.; et al. Diagnosis and management of connective tissue disease-associated interstitial lung disease in Australia and New Zealand: A position statement from the Thoracic Society of Australia and New Zealand. Respirology 2021, 26, 23–51. [Google Scholar] [CrossRef]
- Furini, F.; Carnevale, A.; Casoni, G.L.; Guerrini, G.; Cavagna, L.; Govoni, M.; Sciré, C.A. The Role of the Multidisciplinary Evaluation of Interstitial Lung Diseases: Systematic Literature Review of the Current Evidence and Future Perspectives. Front. Med. 2019, 6, 246. [Google Scholar] [CrossRef]
- Taha, R.; Feteih, M.; Almoallim, H.; Cheikh, M. Pulmonary Manifestations of Connective Tissue Diseases. In Skills in Rheumatology; Springer Publishing: Singapore, 2021. [Google Scholar] [CrossRef]
- Johnson, S.R.; Bernstein, E.J.; Bolster, M.B.; Chung, J.H.; Danoff, S.K.; George, M.D.; Khanna, D.; Guyatt, G.; Mirza, R.D.; Aggarwal, R.; et al. American College of Rheumatology (ACR)/American College of Chest Physicians (CHEST) Guideline for the Screening and Monitoring of Interstitial Lung Disease in People with Systemic Autoimmune Rheumatic Diseases. Arthritis Care Res. 2024, 76, 1070–1082. [Google Scholar] [CrossRef]
- Hannah, J.; Rodziewicz, M.; Mehta, P.; Heenan, K.M.; Ball, E.; Barratt, S.; Carty, S.; Conway, R.; Cotton, C.V.; Cox, S.; et al. The diagnosis and management of systemic autoimmune rheumatic disease-related interstitial lung disease: British Society for Rheumatology guideline scope. Rheumatol. Adv. Pract. 2024, 8, rkae056. [Google Scholar] [CrossRef]
- Kuwana, M.; Bando, M.; Kawahito, Y.; Sato, S.; Suda, T.; Kondoh, Y. Identification and management of connective tissue disease-associated interstitial lung disease: Evidence-based Japanese consensus statements. Expert Rev. Respir. Med. 2023, 17, 71–80. [Google Scholar] [CrossRef]
- Guiot, J.; Miedema, J.; Cordeiro, A.; De Vries-Bouwstra, J.K.; Dimitroulas, T.; Søndergaard, K.; Tzouvelekis, A.; Smith, V. Practical guidance for the early recognition and follow-up of patients with connective tissue disease-related interstitial lung disease. Autoimmunity 2024, 23, 103582. [Google Scholar] [CrossRef]
- Briggs, D.C.; Vaughan, R.W.; Welsh, K.I.; Myers, A.; duBois, R.M.; Black, C.M. Immunogenetic prediction of pulmonary fibrosis in systemic sclerosis. Lancet 1991, 338, 661–662. [Google Scholar] [CrossRef]
- Ashmore, P.; Tikly, M.; Wong, M.; Ickinger, C. Interstitial lung disease in South Africans with systemic sclerosis. Rheumatol. Int. 2018, 38, 657–662. [Google Scholar] [CrossRef]
- Silver, R.M.; Bogatkevich, G.; Tourkina, E.; Nietert, P.J.; Hoffman, S. Racial differences between blacks and whites with systemic sclerosis. Curr. Opin. Rheumatol. 2012, 24, 642–648. [Google Scholar] [CrossRef]
- Steen, V.; Domsic, R.T.; Lucas, M.; Fertig, N.; Medsger, T.A., Jr. A clinical and serologic comparison of African American and Caucasian patients with systemic sclerosis. Arthritis Rheum. 2012, 64, 2986–2994. [Google Scholar] [CrossRef]
- Gong, X.; He, S.; Cai, P. Roles of TRIM21/Ro52 in connective tissue disease-associated interstitial lung diseases. Front. Immunol. 2024, 15, 1435525. [Google Scholar] [CrossRef]
- Zhang, L.; Wu, G.; Gao, D.; Liu, G.; Pan, L.; Ni, L.; Li, Z.; Wang, Q. Factors Associated with Interstitial Lung Disease in Patients with Polymyositis and Dermatomyositis: A Systematic Review and Meta-Analysis. PLoS ONE 2016, 11, e0155381. [Google Scholar] [CrossRef]
- Danko, K.; Ponyi, A.; Constantin, T.; Borgulya, G.; Szegedi, G. Long-term survival of patients with idiopathic inflammatory myopathies according to clinical features: A longitudinal study of 162 cases. Medicine 2004, 83, 35–42. [Google Scholar] [CrossRef]
- Marie, I.; Josse, S.; Decaux, O.; Dominique, S.; Diot, E.; Landron, C.; Roblot, P.; Jouneau, S.; Hatron, P.Y.; Tiev, K.P.; et al. Comparison of long-term outcome between anti-Jo1- and anti-PL7/PL12 positive patients with antisynthetase syndrome. Autoimmun. Rev. 2012, 11, 739–745. [Google Scholar] [CrossRef]
- Cen, X.; Zuo, C.; Yang, M.; Yin, G.; Xie, Q. A clinical analysis of risk factors for interstitial lung disease in patients with idiopathic inflammatory myopathy. Clin. Dev. Immunol. 2013, 2013, 648570. [Google Scholar] [CrossRef]
- Chua, F.; Higton, A.M.; Colebatch, A.N.; O’Reilly, K.; Grubnic, S.; Vlahos, I.; Edwards, C.J.; Kiely, P.D. Idiopathic inflammatory myositis-associated interstitial lung disease: Ethnicity differences and lung function trends in a British cohort. Rheumatology 2012, 51, 1870–1876. [Google Scholar] [CrossRef]
- Shao, C.; Xia, N.; Zhen, Y.; Zhang, X.; Yan, N.; Guo, Q. Prognostic significance of natural killer cell depletion in predicting progressive fibrosing interstitial lung disease in idiopathic inflammatory myopathies. Front. Immunol. 2024, 15, 1404828. [Google Scholar] [CrossRef]
- Zhang, T.; Yuan, F.; Xu, L.; Sun, W.; Liu, L.; Xue, J. Characteristics of patients with interstitial lung disease associated with primary Sjögren’s syndrome and relevant characteristics of disease progression. Clin. Rheumatol. 2020, 39, 1561–1568. [Google Scholar] [CrossRef]
- Zhang, R.; Sun, T.; Song, L.; Zuo, D.; Xiao, W. Increased levels of serum galectin-3 in patients with primary Sjögren’s syndrome: Associated with interstitial lung disease. Cytokine 2014, 69, 289–293. [Google Scholar] [CrossRef]
- Ng, K.H.; Chen, D.Y.; Lin, C.H.; Chao, W.C.; Chen, Y.M.; Chen, Y.H.; Huang, W.N.; Hsieh, T.Y.; Lai, K.L.; Tang, K.T.; et al. Risk of interstitial lung disease in patients with newly diagnosed systemic autoimmune rheumatic disease: A population-based, nationwide cohort study. Semin. Arthritis Rheum. 2020, 50, 840–845. [Google Scholar] [CrossRef]
- Nayebirad, S.; Mohamadi, A.; Yousefi-Koma, H.; Javadi, M.; Farahmand, K.; Atef-Yekta, R.; Tamartash, Z.; Jameie, M.; Mohammadzadegan, A.M.; Kavosi, H. Association of anti-Ro52 autoantibody with interstitial lung disease in autoimmune diseases: A systematic review and meta-analysis. BMJ Open Respir. Res. 2023, 10, e002076. [Google Scholar] [CrossRef]
- Dong, X.; Zhou, J.; Guo, X.; Li, Y.; Xu, Y.; Fu, Q.; Lu, Y.; Zheng, Y. A retrospective analysis of chest HRCT distinctive features and clinical manifestations in interstitial lung disease associated with primary Sjögren’s syndrome in a Chinese population. Clin. Rheumatol. 2018, 37, 2981–2988. [Google Scholar] [CrossRef]
- Santacruz, J.C.; Mantilla, M.J.; Rodriguez-Salas, G.; Rueda, I.; Pulido, S.; Varela, D.C.; Londono, J. Interstitial Lung Disease in Mixed Connective Tissue Disease: An Advanced Search. Cureus 2023, 15, e36204. [Google Scholar] [CrossRef]
- Lot, H.K. Interstitial lung disease in patients with mixed connective tissue disease. Chest 2013, 68, 186. [Google Scholar] [CrossRef]
- Narula, N.; Narula, T.; Mira-Avendano, I.; Wang, B.; Abril, A. Interstitial lung disease in patients with mixed connective tissue disease: Pilot study of predictors of pulmonary involvement. Clin. Exp. Rheumatol. 2018, 36, 648–651. [Google Scholar] [PubMed]
- Lee, C.T.; Strek, M.E. The other connective tissue disease-associated interstitial lung diseases: Sjogren’s syndrome, mixed connective tissue disease, and systemic lupus erythematosus. Curr. Opin. Pulm. Med. 2021, 27, 388–395. [Google Scholar] [CrossRef]
- Good, S.D.; Sparks, J.A.; Volkmann, E.R. Screening, diagnosis, and monitoring of interstitial lung disease in autoimmune rheumatic diseases: A narrative review. Rev. Colomb. Reumatol. 2024, 31, S3–S14. [Google Scholar] [CrossRef] [PubMed]
- Tekaya, A.B.; Mokaddem, S.; Athimini, S.; Kamoun, H.; Mahmoud, I.; Abdelmoula, L. Risk factors for rheumatoid arthritis-associated interstitial lung disease: A retrospective study. Multidiscip. Respir. Med. 2022, 17, 877. [Google Scholar] [CrossRef]
- Paulin, F.; Doyle, T.J.; Mercado, J.F.; Fassola, L.; Fernández, M.; Caro, F.; Alberti, M.L.; Espíndola, M.E.C.; Buschiazzo, E. Development of a risk indicator score for the identification of interstitial lung disease in patients with rheumatoid arthritis. Reumatol. Clin. 2021, 17, 207–211. [Google Scholar] [CrossRef] [PubMed]
- Zhang, M.; Yin, J.; Zhang, X. Factors associated with interstitial lung disease in patients with rheumatoid arthritis: A systematic review and meta-analysis. PLoS ONE 2023, 18, e0286191. [Google Scholar] [CrossRef] [PubMed]
- Habib, H.M.; Eisa, A.A.; Arafat, W.R.; Marie, M.A. Pulmonary involvement in early rheumatoid arthritis patients. Clin. Rheumatol. 2011, 30, 217–222. [Google Scholar] [CrossRef]
- Mohning, M.P.; Amigues, I.; Demoruelle, M.K.; Fernández Pérez, E.R.; Huie, T.J.; Keith, R.K.; Olson, A.L.; Yunt, Z.X.; Chung, J.H.; Hobbs, S.; et al. Duration of rheumatoid arthritis and the risk of developing interstitial lung disease. ERJ Open Res. 2021, 7, 00633–2020. [Google Scholar] [CrossRef] [PubMed]
- Rojas-Serrano, J.; Mejía, M.; Rivera-Matias, P.A.; Herrera-Bringas, D.; Pérez-Román, D.I.; Pérez-Dorame, R.; Mateos-Toledo, H. Rheumatoid arthritis-related interstitial lung disease (RA-ILD): A possible association between disease activity and prognosis. Clin. Reumathol. 2022, 41, 1741–1747. [Google Scholar] [CrossRef] [PubMed]
- Gochuico, B.R.; Avila, N.A.; Chow, C.K.; Novero, L.J.; Wu, H.P.; Ren, P.; MacDonald, S.D.; Travis, W.D.; Stylianou, M.P.; Rosas, I.O. Progressive preclinical interstitial lung disease in rheumatoid arthritis. Arch. Intern. Med. 2008, 168, 159–166. [Google Scholar] [CrossRef] [PubMed]
- Mori, S.; Koga, Y.; Sugimoto, M. Different risk factors between interstitial lung disease and airway disease in rheumatoid arthritis. Respir. Med. 2012, 106, 1591–1599. [Google Scholar] [CrossRef] [PubMed]
- Zou, Y.Q.; Li, Y.S.; Ding, X.N.; Ying, Z.H. The clinical significance of HRCT in evaluation of patients with rheumatoid arthritis-associated interstitial lung disease: A report from China. Rheumatol. Int. 2012, 32, 669–673. [Google Scholar] [CrossRef]
- Aubart, F.; Crestani, B.; Nicaise-Roland, P.; Tubach, F.; Bollet, C.; Dawidowicz, K.; Quintin, E.; Hayem, G.; Palazzo, E.; Meyer, O.; et al. High levels of anti-cyclic citrullinated peptide autoantibodies are associated with co-occurrence of pulmonary diseases with rheumatoid arthritis. J. Reumatol. 2022, 2011, 979–982. [Google Scholar] [CrossRef] [PubMed]
- Zhang, Y.; Li, H.; Wu, N.; Dong, X.; Zheng, Y. Retrospective study of clinical characteristics and risk factors of interstitial lung disease associated with rheumatoid arthritis. Clin. Rheumatol. 2017, 36, 817–823.33. [Google Scholar] [CrossRef]
- Wang, N.; Zhang, Q.; Jing, X.; Guo, J.; Huang, H.; Xu, Z. The Association Between MUC5B Mutations and Clinical Outcome in Patients with Rheumatoid Arthritis-Associated Interstitial Lung Disease: A Retrospective Exploratory Study in China. Med. Sci. Monit. 2020, 26, e920137. [Google Scholar] [CrossRef] [PubMed]
- Narváez, J.; Borrell, H.; Sánchez-Alonso, F.; Rúa-Figueroa, I.; López-Longo, F.J.; Galindo-Izquierdo, M.; Calvo-Alén, J.; Fernández-Nebro, A.; Olivé, A.; Andreu, J.L.; et al. Primary respiratory disease in patients with systemic lupus erythematosus: Data from the Lupus Registry of the Spanish Society of Rheumatology (RELESSER) cohort. Arthritis Res. Ther. 2018, 20, 280. [Google Scholar] [CrossRef] [PubMed]
- Amarnani, R.; Yeoh, S.A.; Denneny, E.K.; Wincup, C. Lupus and the lungs: Evaluation and management of pulmonary manifestations of systemic lupus erythematosus. Front. Med. 2020, 7, 610257. [Google Scholar] [CrossRef]
- Jee, A.S.; Adelstein, S.; Bleasel, J.; Keir, G.J.; Nguyen, M.; Sahhar, J.; Youssef, P.; Corte, T.J. Role of Autoantibodies in the Diagnosis of Connective-Tissue Disease ILD (CTD-ILD) and Interstitial Pneumonia with Autoimmune Features (IPAF). J. Clin. Med. 2017, 6, 51. [Google Scholar] [CrossRef] [PubMed]
- Nair, A.; Walsh, S.L.; Desai, S.R. Imaging of pulmonary involvement in rheumatic disease. Rheum. Dis. Clin. N. Am. 2015, 41, 167–196. [Google Scholar] [CrossRef] [PubMed]
- Bryson, T.; Sundaram, B.; Khanna, D.; Kazerooni, E.A. Connective tissue disease-associated interstitial pneumonia and idiopathic interstitial pneumonia: Similarity and difference. Semin. Ultrasound CT MR 2014, 35, 29–38. [Google Scholar] [CrossRef]
- Lynch, D.A. Lung disease related to collagen vascular disease. J. Thorac. Imaging 2009, 24, 299–309. [Google Scholar] [CrossRef]
- Mueller-Mang, C.; Ringl, H.; Herold, C. Interstitial Lung Diseases. Multislice CT 2017, 24, 261–288. [Google Scholar] [CrossRef]
- Elicker, B.; Pereira, C.A.; Webb, R.; Leslie, K.O. High-resolution computed tomography patterns of diffuse interstitial lung disease with clinical and pathological correlation. J. Bras. Pneumol. 2008, 34, 715–744. [Google Scholar] [CrossRef]
- Lucà, S.; Pagliuca, F.; Perrotta, F.; Ronchi, A.; Mariniello, D.F.; Natale, G.; Bianco, A.; Fiorelli, A.; Accardo, M.; Franco, R. Multidisciplinary Approach to the Diagnosis of Idiopathic Interstitial Pneumonias: Focus on the Pathologist’s Key Role. Int. J. Mol. Sci. 2024, 25, 3618. [Google Scholar] [CrossRef]
- Palmucci, S.; Galioto, F.; Fazio, G.; Ferlito, A.; Cancemi, G.; Di Mari, A.; Sambataro, G.; Sambataro, D.; Zanframundo, G.; Mauro, L.A.; et al. Clinical and radiological features of lung disorders related to connective-tissue diseases: A pictorial essay. Insights Imaging 2022, 13, 108. [Google Scholar] [CrossRef]
- Kalchiem-Dekel, O.; Galvin, J.R.; Burke, A.P.; Atamas, S.P.; Todd, N.W. Interstitial Lung Disease and Pulmonary Fibrosis: A Practical Approach for General Medicine Physicians with Focus on the Medical History. J. Clin. Med. 2018, 7, 476. [Google Scholar] [CrossRef]
- Luppi, F.; Manfredi, A.; Faverio, P.; Andersen, M.B.; Bono, F.; Pagni, F.; Salvarani, C.; Bendstrup, E.; Sebastiani, M. The usual Interstitial pneumonia pattern in autoimmune rheumatic diseases. BMC Pulm. Med. 2023, 23, 501. [Google Scholar] [CrossRef]
- Radzikowska, E.; Fijolek, J. Update on cryptogenic organizing pneumonia. Front. Med. 2023, 10, 1146782. [Google Scholar] [CrossRef]
- Diken, Ö.E.; Şengül, A.; Coşkun Beyan, A.; Ayten, Ö.; Mutlu, L.C.; Okutan, O. Desquamative interstitial pneumonia: Risk factors, laboratory and bronchoalveolar lavage findings, radiological and histopathological examination, clinical features, treatment and prognosis (Review). Exp. Ther. Med. 2019, 17, 587–595. [Google Scholar] [CrossRef]
- Hartman, T.E.; Primack, S.L.; Swensen, S.J.; Hansell, D.; McGuinness, G.; Müller, N.L. Desquamative interstitial pneumonia: Thin-section CT findings in 22 patients. Radiology 1993, 187, 787–790. [Google Scholar] [CrossRef]
- Tomassetti, S.; Colby, T.V.; Wells, A.U.; Poletti, V.; Costabel, U.; Matucci-Cerinic, M. Bronchoalveolar lavage and lung biopsy in connective tissue diseases, to do or not to do? Ther. Adv. Musculoskelet. Dis. 2021, 8, 1759720X211059605. [Google Scholar] [CrossRef]
- Louza, G.F.; Nobre, L.F.; Mançano, A.D.; Hochhegger, B.; Souza, A.S.; Zanetti, G.; Marchiori, E. Lymphocytic interstitial pneumonia: Computed tomography findings in 36 patients. Radiol. Bras. 2020, 53, 287–292. [Google Scholar] [CrossRef]
- Doyle, T.J.; Dellaripa, P.F. Lung Manifestations in the Rheumatic Diseases. Chest 2017, 152, 1283–1295. [Google Scholar] [CrossRef]
- Silverstone, L.; Campos, A.; Saber, M. Connective Tissue Disease-Related Interstitial lung Disease (CTD-ILD). Available online: https://radiopaedia.org (accessed on 30 October 2024). [CrossRef]
- Rao, P.P.G.; Joshi, K.; Liyanage, S.; Dalili, D.; Koduri, G. Imaging in Connective Tissue Disease-Associated Interstitial Lung Disease. Indian J. Rheumatol. 2021, 16, S58–S68. [Google Scholar] [CrossRef]
- Bouros, D.; Nicholson, A.C.; Polychronopoulos, V.; du Bois, R.M. Acute interstitial pneumonia. Eur. Respir. J. 2000, 15, 412–418. [Google Scholar] [CrossRef]
- Wells, J.; Frankel, S.K. Alveolar Hemorrhage. Orphan Lung Dis. 2014, 11, 155–175. [Google Scholar] [CrossRef]
- Gutsche, M.; Rosen, G.D.; Swigris, J.J. Connective Tissue Disease-associated Interstitial Lung Disease: A review. Curr. Respir. Care Rep. 2012, 21, 224–232. [Google Scholar] [CrossRef]
- Solomon, J.J.; Chung, J.H.; Cosgrove, G.P.; Demoruelle, M.K.; Fernandez-Perez, E.R.; Fischer, A.; Frankel, S.K.; Hobbs, S.B.; Huie, T.J.; Ketzer, J.; et al. Predictors of mortality in interstitial lung disease associated with rheumatoid arthritis. Eur. Respir. J. 2016, 47, 588–596. [Google Scholar] [CrossRef]
- Ciancio, N.; Pavone, M.; Torrisi, S.E.; Vancheri, A.; Sambataro, D.; Palmucci, S.; Vancheri, C.; Di Marco, F.; Sambataro, G. Contribution of pulmonary function tests (PFTs) to the diagnosis and follow up of connective tissue diseases. Multidiscip. Respir. Med. 2019, 14, 17. [Google Scholar] [CrossRef]
- Kumar, D.P. Evaluation and follow-up of interstitial lung disease. Indian J. Rheumatol. 2021, 16, S69–S78. [Google Scholar] [CrossRef]
- Martinez-Pitre, P.J.; Sabbula, B.R.; Cascella, M. Restrictive Lung Disease. In StatPearls [Internet]; StatPearls Publishing: Treasure Island, FL, USA, 2024. [Google Scholar] [PubMed]
- Wilson, T.M.; Solomon, J.J.; Demoruelle, M.K. Treatment approach to connective tissue disease-associated interstitial lung disease. Curr. Opin. Pharmacol. 2022, 65, 102245. [Google Scholar] [CrossRef]
- Johnson, D.C. Pulmonary Function Tests and Interstitial Lung Disease. Chest 2021, 159, 1304. [Google Scholar] [CrossRef]
- Criée, C.P.; Sorichter, S.; Smith, H.J.; Kardos, P.; Merget, R.; Heise, D.; Berdel, D.; Köhler, D.; Magnussen, H.; Marek, W.; et al. Working Group for Body Plethysmography of the German Society for Pneumology and Respiratory Care. Body plethysmography—Its principles and clinical use. Respir. Med. 2011, 105, 959–971. [Google Scholar] [CrossRef]
- Torén, K.; Schiöler, L.; Brisman, J.; Malinovschi, A.; Olin, A.-C.; Bergström, G.; Bake, B. Restrictive spirometric pattern and true pulmonary restriction in a general population sample aged 50–64 years. BMC Pulm. Med. 2020, 20, 55. [Google Scholar] [CrossRef]
- Ruppel, G.L. What is the clinical value of lung volumes? Respir. Care 2012, 57, 26–35. [Google Scholar] [CrossRef] [PubMed]
- Miller, M.R.; Hankinson, J.; Brusasco, V.; Burgos, F.; Casaburi, R.; Coates, A.; Crapo, R.; Enright, P.; van der Grinten, C.P.; Gustafsson, P.; et al. ATS/ERS Task Force. Standardisation of spirometry. Eur. Respir. J. 2005, 26, 319–338. [Google Scholar] [CrossRef]
- Modi, P.; Goldin, J.; Cascella, M. Diffusing Capacity of the Lungs for Carbon Monoxide. In StatPearls [Internet]; StatPearls Publishing: Treasure Island, FL, USA, 2024. [Google Scholar] [PubMed]
- Faverio, P.; De Giacomi, F.; Bonaiti, G.; Stainer, A.; Sardella, L.; Pellegrino, G.; Sferrazza Papa, G.F.; Bini, F.; Bodini, B.D.; Carone, M.; et al. Management of Chronic Respiratory Failure in Interstitial Lung Diseases: Overview and Clinical Insights. Int. J. Med. Sci. 2019, 16, 967–980. [Google Scholar] [CrossRef]
- Caminati, A.; Cassandro, R.; Harari, S. Pulmonary hypertension in chronic interstitial lung diseases. Eur. Respir. Rev. 2013, 22, 292–301. [Google Scholar] [CrossRef]
- Harari, S.; Wells, A.U.; Wuyts, W.A.; Nathan, S.D.; Kirchgaessler, K.U.; Bengus, M.; Behr, J. The 6-min walk test as a primary end-point in interstitial lung disease. Eur. Respir. Rev. 2022, 31, 220087. [Google Scholar] [CrossRef]
- Dowman, L.; Hill, C.J.; Holland, A.E. Pulmonary rehabilitation for interstitial lung disease. Cochrane Database Syst. Rev. 2014, 10, CD006322, Update in Cochrane Database Syst. Rev. 2021, 2, CD006322. [Google Scholar] [CrossRef]
- Fischer, A.; du Bois, R. Interstitial lung disease in connective tissue disorders. Lancet 2012, 380, 689–698. [Google Scholar] [CrossRef]
- Sugino, K.; Otsuka, H.; Matsumoto, Y.; Nakamura, Y.; Matsumoto, K.; Azuma, Y.; Makino, T.; Iyoda, A.; Shibuya, K.; Homma, S. The role of video-assisted thoracoscopic surgery in the diagnosis of interstitial lung disease. Sarcoidosis Vasc. Diffuse Lung Dis. 2019, 36, 148–156. [Google Scholar] [CrossRef]
- Efared, B.; Ebang-Atsame, G.; Rabiou, S.; Diarra, A.S.; Tahiri, L.; Hammas, N.; Smahi, M.; Amara, B.; Benjelloun, M.C.; Serraj, M.; et al. The diagnostic value of the bronchoalveolar lavage in interstitial lung diseases. J. Negat. Results Biomed. 2017, 16, 4. [Google Scholar] [CrossRef]
- Stanzel, F. Bronchoalveolar Lavage. In Principles and Practice of Interventional Pulmonology; Springer: New York, NY, USA, 2012; Volume 22, pp. 165–176. [Google Scholar] [CrossRef]
- Chiang, G.C.; ParimonM, T. Understanding Interstitial Lung Diseases Associated with Connective Tissue Disease (CTD-ILD): Genetics, Cellular Pathophysiology, and Biologic Drivers. Int. J. Mol. Sci. 2023, 24, 2405. [Google Scholar] [CrossRef]
- Davidson, K.R.; Ha, D.M.; Schwarz, M.I.; Chan, E.D. Bronchoalveolar lavage as a diagnostic procedure: A review of known cellular and molecular findings in various lung diseases. J. Thorac. Dis. 2020, 12, 4991–5019. [Google Scholar] [CrossRef]
- Geerts, S.; Wuyts, W.; Langhe, E.; Lenaerts, J.; Yserbyt, J. Connective tissue disease associated interstitial pneumonia: A challenge for both rheumatologists and pulmonologists. Sarcoidosis Vasc. Diffuse Lung Dis. 2017, 34, 326–335. [Google Scholar] [CrossRef]
- Zhou, A.; Tang, H.; Peng, W.; Wang, Y.; Tang, X.; Yang, H.; Lu, R.; Pan, P. KL-6 levels in the connective tissue disease population: Typical values and potential confounders-a retrospective, real-world study. Front. Immunol. 2023, 14, 1098602. [Google Scholar] [CrossRef]
- Wei, F.; Zhang, X.; Yang, S.; Geng, J.; Xie, B.; Ren, Y.; Dai, H. Evaluation of the Clinical Value of KL-6 and Tumor Markers in Primary Sjögren’s Syndrome Complicated with Interstitial Lung Disease. J. Clin. Med. 2023, 12, 4926. [Google Scholar] [CrossRef]
- Bao, Y.; Zhang, W.; Shi, D.; Bai, W.; He, D.; Wang, D. Correlation Between Serum Tumor Marker Levels and Connective Tissue Disease-Related Interstitial Lung Disease. Int. J. Gen. Med. 2021, 14, 2553–2560. [Google Scholar] [CrossRef]
- Wang, T.; Zheng, X.-J.; Ji, Y.-L.; Liang, Z.-A.; Liang, B.-M. Tumor markers in rheumatoid arthritis-associated interstitial lung disease. Clin. Ex. Rheumatol. 2016, 34, 587–591. [Google Scholar] [PubMed]
- Takahashi, H.; Kuroki, Y.; Tanaka, H.; Saito, T.; Kurokawa, K.; Chiba, H.; Sagawa, A.; Nagae, H.; Abe, S. Serum levels of surfactant proteins A and D are useful biomarkers for interstitial lung disease in patients with progressive systemic sclerosis. Am. J. Respir. Crit. Care Med. 2000, 162, 258–263. [Google Scholar] [CrossRef]
- Yamakawa, H.; Hagiwara, E.; Kitamura, H.; Yamanaka, Y.; Ikeda, S.; Sekine, A.; Baba, T.; Okudela, K.; Iwasawa, T.; Takemura, T.; et al. Serum KL-6 and surfactant protein-D as monitoring and predictive markers of interstitial lung disease in patients with systemic sclerosis and mixed connective tissue disease. J. Thorac. Dis. 2017, 9, 362–371. [Google Scholar] [CrossRef]
- Györfi, A.H.; Filla, T.; Dickel, N.; Möller, F.; Li, Y.N.; Bergmann, C.; Matei, A.E.; Harrer, T.; Kunz, M.; Schett, G.; et al. Performance of serum biomarkers reflective of different pathogenic processes in systemic sclerosis-associated interstitial lung disease. Rheumatology 2024, 63, 962–969. [Google Scholar] [CrossRef]
- Olewicz-Gawlik, A.; Trzybulska, D.; Kuznar-Kaminska, B.; Katulska, K.; Danczak-Pazdrowska, A.; Batura-Gabryel, H.; Hrycaj, P. Serum Clara cell 16-kDa protein levels and lung impairment in systemic sclerosis patients. Rev. Bras. Rheumatol. Engl. 2016, 56, 309–313. [Google Scholar] [CrossRef][Green Version]
- Hasegawa, M.; Fujimoto, M.; Hamaguchi, Y.; Matsushita, T.; Inoue, K.; Sato, S.; Takehara, K. Use of serum clear cell 16-kDa (CC16) levels as a potential indicator of active pulmonary fibrosis in systemic sclerosis. J. Rheumatol. 2011, 38, 877–884. [Google Scholar] [CrossRef]
- Fields, A.; Potel, K.N.; Cabuhal, R.; Aziri, B.; Stewart, I.D.; Schock, B.C. Mediators of systemic sclerosis-associated interstitial lung disease (SSc-ILD): Systematic review and meta-analyses. Thorax 2023, 78, 799–807. [Google Scholar] [CrossRef]
- Kawasumi, H.; Gono, T.; Kawaguchi, Y.; Kaneko, H.; Katsumata, Y.; Hanaoka, M.; Kataoka, S.; Yamanaka, H. IL-6, IL-8, and IL-10 are associated with hyperferritinemia in rapidly progressive interstitial lung disease with polymyositis/dermatomyositis. BioMed. Res. Int. 2014, 2014, 815245. [Google Scholar] [CrossRef]
- Wu, M.; Baron, M.; Pedroza, C.; Salazar, G.A.; Ying, J.; Charles, J.; Agarwal, S.K.; Hudson, M.; Pope, J.; Zhou, X.; et al. CCL2 in the Circulation Predicts Long-Term Progression of Interstitial Lung Disease in Patients With Early Systemic Sclerosis. Arthritis Rheumatol. 2017, 69, 1871–1878. [Google Scholar] [CrossRef]
- Wu, C.Y.; Li, L.; Zhang, L.H. Detection of serum MCP-1 and TGF-β1 in polymyositis/dermatomyositis patients and its significance. Eur. J. Med. Res. 2019, 24, 12. [Google Scholar] [CrossRef]
- Nara, M.; Komatsuda, A.; Omokawa, A.; Togashi, M.; Okuyama, S.; Sawada, K.; Wakui, H. Serum interleukin 6 levels as a useful prognostic predictor of clinically amyopathic dermatomyositis with rapidly progressive interstitial lung disease. Mod. Rheumatol. 2014, 24, 633–636. [Google Scholar] [CrossRef]
- Zanatta, E.; Martini, A.; Depascale, R.; Gamba, A.; Tonello, M.; Gatto, M.; Giraudo, C.; Balestro, E.; Doria, A.; Iaccarino, L. CCL18 as a Biomarker of Interstitial Lung Disease (ILD) and Progressive Fibrosing ILD in Patients with Idiopathic Inflammatory Myopathies. Diagnostis 2023, 13, 1715. [Google Scholar] [CrossRef]
- Tong, X.; Ma, Y.; Liu, T.; Li, Z.; Liu, S.; Wu, G.; Fan, H. Can YKL-40 be used as a biomarker for interstitial lung disease?: A systematic review and meta-analysis. Medicine 2021, 100, e25631. [Google Scholar] [CrossRef]
- Kawanabe, R.; Yoshizaki, A.; Matsuda, K.M.; Kotani, H.; Hisamoto, T.; Norimatsu, Y.; Kuzumi, A.; Fukasawa, T.; Ebata, S.; Yoshizaki-Ogawa, A.; et al. Serum C-X-C Chemokine Ligand 1 Levels in Patients with Systemic Sclerosis: Relationship of Clinical and Laboratory Observations to Anti-CD20 Antibody. Life 2022, 12, 646. [Google Scholar] [CrossRef]
- Furuse, S.; Fujii, H.; Kaburagi, Y.; Fujimoto, M.; Hasegawa, M.; Takehara, K.; Sato, S. Serum concentrations of the CXC chemokines interleukin 8 and growth-regulated oncogene-alpha are elevated in patients with systemic sclerosis. J. Rheumatol. 2003, 30, 1524–1528. [Google Scholar] [PubMed]
- Al-Adwi, Y.; Atzeni, I.M.; Doornbos-van der Meer, B.; van der Leij, M.J.; Varkevisser, R.D.M.; Kroesen, B.J.; Stel, A.; Timens, W.; Gan, C.T.; van Goor, H.; et al. High serum C-X-C motif chemokine ligand 10 (CXCL10) levels may be associated with new onset interstitial lung disease in patients with systemic sclerosis: Evidence from observational, clinical, transcriptomic and in vitro studies. eBioMedicine 2023, 98, 104883. [Google Scholar] [CrossRef]
- Chen, J.; Doyle, T.J.; Liu, Y.; Aggarwal, R.; Wang, X.; Shi, Y.; Ge, S.X.; Huang, H.; Lin, Q.; Liu, W.; et al. Biomarkers of rheumatoid arthritis-associated lung disease. Arthritis Rheumatol. 2015, 67, 28–38. [Google Scholar] [CrossRef]
- Zhu, T.; Pan, Z.; Zhang, N. Elevated CXCL13 in primary Sjögren’s syndrome and its correlation with disease activity: A systematic review and meta-analysis. Clin. Rheumatol. 2022, 41, 2791–2802. [Google Scholar] [CrossRef]
- Gao, S.-H.; Liu, S.-Z.; Wang, G.-Z.; Zhou, G.-B. CXCL13 in cancer and other diseases: Biological functions, clinical significance and therapeutic opportunities. Life 2021, 11, 1282. [Google Scholar] [CrossRef]
- Wang, G.Z.; Cheng, X.; Zhou, B.; Wen, Z.S.; Huang, Y.C.; Chen, H.B.; Li, G.F.; Huang, Z.L.; Zhou, Y.C.; Feng, L.; et al. The chemokine CXCL13 in lung cancers associated with environmental polycyclic aromatic hydrocarbons pollution. eLife 2015, 4, e09419. [Google Scholar] [CrossRef]
- Istrate-Ofiţeru, A.M.; Mogoantă, C.A.; Zorilă, G.L.; Roşu, G.C.; Drăguşin, R.C.; Berbecaru, E.I.; Zorilă, M.V.; Comănescu, C.M.; Mogoantă, S.Ș.; Vaduva, C.C.; et al. Clinical Characteristics and Local Histopathological Modulators of Endometriosis and Its Progression. Int. J. Mol. Sci. 2024, 25, 1789. [Google Scholar] [CrossRef]
- Chen, H.; Tang, J.; Liang, J.; Huang, D.; Pan, C.; Liu, S.; Du, X.; Tao, L. Clinical association study on the matrix metalloproteinase expression in the serum of patients with connective tissue disease complicated with interstitial lung disease. Arch. Rheumatol. 2023, 38, 367–374. [Google Scholar] [CrossRef]
- Chengna, L.V.; Zhang, Q.; Tang, P.; Guo, L.; Ding, Q. Serum MMP-9, SP-D, and VEGF levels reflect the severity of connective tissue disease-associated interstitial lung diseases. Adv. Rheumatol. 2022, 62, 37. [Google Scholar] [CrossRef]
- Juge, P.A.; Lee, J.S.; Ebstein, E.; Furukawa, H.; Dobrinskikh, E.; Gazal, S.; Kannengiesser, C.; Ottaviani, S.; Oka, S.; Tohma, S.; et al. MUC5B Promoter Variant and Rheumatoid Arthritis with Interstitial Lung Disease. N. Engl. J. Med. 2018, 379, 2209–2219. [Google Scholar] [CrossRef]
- Stock, C.J.W.; Renzoni, E.A. Telomeres in Interstitial Lung Disease. J. Clin. Med. 2021, 10, 1384. [Google Scholar] [CrossRef]
- Cottin, V.; Martinez, F.J.; Smith, V.; Walsh, S.L.F. Multidisciplinary teams in the clinical care of fibrotic interstitial lung disease: Current perspectives. Eur. Respir. Rev. 2022, 31, 220003. [Google Scholar] [CrossRef]
- Case, A.H.; Beegle, S.; Hotchkin, D.L.; Kaelin, T.; Kim, H.J.; Podolanczuk, A.J.; Ramaswamy, M.; Remolina, C.; Salvatore, M.M.; Tu, C.; et al. Defining the pathway to timely diagnosis and treatment of interstitial lung disease: A US Delphi survey. BMJ Open Respir. Res. 2023, 10, e001594. [Google Scholar] [CrossRef]
- De Lorenzis, E.; Bosello, S.L.; Varone, F.; Sgalla, G.; Calandriello, L.; Natalello, G.; Iovene, B.; Cicchetti, G.; Gigante, L.; Verardi, L.; et al. Multidisciplinary Evaluation of Interstitial Lung Diseases: New Opportunities Linked to Rheumatologist Involvement. Diagnostics 2020, 10, 664. [Google Scholar] [CrossRef]
- Sverzellati, N.; Odone, A.; Silva, M.; Polverosi, R.; Florio, C.; Cardinale, L.; Cortese, G.; Addonisio, G.; Zompatori, M.; Dalpiaz, G.; et al. Structured reporting for fibrosing lung disease: A model shared by radiologist and pulmonologist. Radiol. Med. 2018, 123, 245–253. [Google Scholar] [CrossRef]
- Fairley, J.L.; Ross, L.; Burns, A.; Prior, D.; Conron, M.; Rouse, H.; McDonald, J.; MacIsaac, A.; La Gerche, A.; Morrisroe, K.; et al. Multidisciplinary team discussion: The emerging gold standard for management of cardiopulmonary complications of connective tissue disease. Intern. Med. J. 2023, 53, 1919–1924. [Google Scholar] [CrossRef]
- Khan, M.A.; Sherbini, N.; Alyami, S.; Al-Harbi, A.; Alrajhi, S.; Abdullah, R.; AlGhamdi, D.; Rajendram, R.; Bamefleh, H.; Al-Jahdali, H. Role of Multidisciplinary Team Meetings in the Diagnosis and Management of Diffuse Parenchymal Lung Diseases in a Tertiary Care Hospital. Avicenna J. Med. 2023, 13, 230–236. [Google Scholar] [CrossRef]
- Rahaghi, F.F.; Hsu, V.M.; Kaner, R.J.; Mayes, M.D.; Rosas, I.O.; Saggar, R.; Steen, V.D.; Strek, M.E.; Bernstein, E.J.; Bhatt, N.; et al. Expert consensus on the management of systemic sclerosis-associated interstitial lung disease. Respir. Res. 2023, 24, 6. [Google Scholar] [CrossRef]
- Kondoh, Y.; Bando, M.; Kawahito, Y.; Sato, S.; Suda, T.; Kuwana, M. Identification and management of interstitial lung disease associated with systemic sclerosis (SSc-ILD), rheumatoid arthritis (RA-ILD), and polymyositis/dermatomyositis (PM/DM-ILD): Development of expert consensus-based clinical algorithms. Expert Rev. Respir. Med. 2024, 18, 447–456. [Google Scholar] [CrossRef]
- Morais, A.; Duarte, A.C.; Fernandes, M.O.; Borba, A.; Ruano, C.; Marques, I.D.; Calha, J.; Branco, J.C.; Pereira, J.M.; Salvador, M.J.; et al. Early detection of interstitial lung disease in rheumatic diseases: A joint statement from the Portuguese Pulmonology Society, the Portuguese Rheumatology Society, and the Portuguese Radiology and Nuclear Medicine Society. Pulmonology 2023. [Google Scholar] [CrossRef]
- Roofeh, D.; Jaafar, S.; Vummidi, D.; Khanna, D. Management of systemic sclerosis-associated interstitial lung disease. Curr. Opin. Rheumatol. 2019, 31, 241–249. [Google Scholar] [CrossRef]
- Khanna, S.A.; Nance, J.W.; Suliman, S.A. Detection and monitoring of interstitial lung disease in patients with systemic sclerosis. Curr. Rheumatol. Rep. 2022, 24, 166–173. [Google Scholar] [CrossRef] [PubMed]
- Khanna, D.; Distler, O.; Cottin, V.; Brown, K.K.; Chung, L.; Goldin, J.G.; Matteson, E.L.; Kazerooni, E.A.; Walsh, S.L.; McNitt-Gray, M.; et al. Diagnosis and monitoring of systemic sclerosis-associated interstitial lung disease using high-resolution computed tomography. J. Scleroderma Relat. Disord. 2022, 7, 168–178. [Google Scholar] [CrossRef]
- Hachulla, E.; Agard, C.; Allanore, Y.; Avouac, J.; Bader-Meunier, B.; Belot, A.; Berezne, A.; Bouthors, A.S.; Condette-Wojtasik, G.; Constans, J.; et al. French recommendations for the management of systemic sclerosis. Orphanet J. Rare Dis. 2021, 6, 322. [Google Scholar] [CrossRef]
- Giucă, A.; Mihai, C.; Jurcuț, C.; Gheorghiu, A.M.; Groșeanu, L.; Dima, A.; Săftoiu, A.; Coman, I.M.; Popescu, B.A.; Jurcuț, R. Screening for Pulmonary Hypertension in Systemic Sclerosis-A Primer for Cardio-Rheumatology Clinics. Diagnostics 2021, 1, 1013. [Google Scholar] [CrossRef]
- Alves, M.R.; Isenberg, D. A “Mixed connective tissue disease”: A condition in search of an identity. Clin. Exp. Med. 2020, 20, 159–166. [Google Scholar] [CrossRef]
- Fairley, J.L.; Hansen, D.; Proudman, S.; Sahhar, J.; Ngian, G.S.; Walker, J.; Strickland, G.; Wilson, M.; Morrisroe, K.; Ferdowsi, N.; et al. Clinical features of systemic sclerosis-mixed connective tissue disease and systemic sclerosis overlap syndromes. Arthritis Care Res. 2021, 73, 732–741. [Google Scholar] [CrossRef]
- Yoo, H.; Hino, T.; Hwang, J.; Franks, T.J.; Han, J.; Im, Y.; Lee, H.Y.; Chung, M.P.; Hatabu, H.; Lee, K.S. Connective tissue disease-related interstitial lung disease (CTD-ILD) and interstitial lung abnormality (ILA): Evolving concept of CT findings, pathology and management. Eur. J. Radiol. Open 2022, 9, 100419. [Google Scholar] [CrossRef]
- Agarwal, M.; Gupta, M.L.; Deokar, K.; Shadrach, B.J.; Bharti, N.; Sonigra, M. Clinico-radiological profile of connective tissue disease related-interstitial lung diseases from a tertiary care centre of India: A cross sectional study. Monaldi Arch. Chest Dis. 2021, 91, 1624. [Google Scholar] [CrossRef] [PubMed]
- Kawano-Dourado, L.; Baldi, B.G.; Kay, F.U.; Dias, O.M.; Gripp, T.E.; Gomes, P.S.; Fuller, R.; Caleiro, M.T.; Kairalla, R.A.; Carvalho, C.R. Pulmonary involvement in long-term mixed connective tissue disease: Functional trends and imaging findings after 10 years. Clin. Exp. Rheumatol. 2015, 33, 234–240. [Google Scholar]
- Bodolay, E.; Szekanecz, Z.; Dévényi, K.; Galuska, L.; Csipo, I.; Vègh, J.; Garai, I.; Szegedi, G. Evaluation of interstitial lung disease in mixed connective tissue disease (MCTD). Rheumatology 2005, 44, 656–661. [Google Scholar] [CrossRef]
- Vu, T.T.T.; Brown, K.K.; Solomon, J.J. Myositis-associated interstitial lung disease. Curr. Opin. Pulm. Med. 2023, 29, 427–435. [Google Scholar] [CrossRef]
- Thong, L.; Chawke, L.J.; Murphy, G.; Henry, M.T. Management of myositis associated interstitial lung disease. Rheumatol. Int. 2023, 43, 1209–1220. [Google Scholar] [CrossRef]
- Laporte, A.; Mariampillai, K.; Allenbach, Y.; Pasi, N.; Donciu, V.; Toledano, D.; Granger, B.; Benveniste, O.; Grenier, P.A.; Boussouar, S. Idiopathic inflammatory myopathies: CT characteristics of interstitial lung disease and their association(s) with myositis-specific autoantibodies. Eur. Radiol. 2022, 32, 3480–3489. [Google Scholar] [CrossRef]
- La Rocca, G.; Ferro, F.; Sambataro, G.; Elefante, E.; Fonzetti, S.; Fulvio, G.; Navarro, I.C.; Mosca, M.; Baldini, C. Primary-Sjögren’s-Syndrome-Related Interstitial Lung Disease: A Clinical Review Discussing Current Controversies. J. Clin. Med. 2023, 12, 3428. [Google Scholar] [CrossRef]
- Lee, A.S.; Scofield, R.H.; Hammitt, K.M.; Gupta, N.; Thomas, D.E.; Moua, T.; Ussavarungsi, K.; Clair, E.W.; Meehan, R.; Dunleavy, K.; et al. Consensus Guidelines for Evaluation and Management of Pulmonary Disease in Sjögren’s. Chest 2021, 159, 683–698. [Google Scholar] [CrossRef]
- Kelly, C.; Gardiner, P.; Pal, B.; Griffiths, I. Lung function in primary Sjögren’s syndrome: A cross sectional and longitudinal study. Thorax 1991, 46, 180–183. [Google Scholar] [CrossRef]
- Reina, D.; Vilaseca, D.; Torrente-Segarra, V.; Cerdà, D.; Castellví, I.; Díaz Torné, C.; Moreno, M.; Narváez, J.; Ortiz, V.; Blavia, R.; et al. Sjögren’s syndrome-associated interstitial lung disease: A multicenter study. Reumatol. Clin. 2016, 12, 201–205. [Google Scholar] [CrossRef]
- Luppi, F.; Sebastiani, M.; Sverzellati, N.; Cavazza, A.; Salvarani, C.; Manfredi, A. Lung complications of Sjogren syndrome. Eur. Respir. Rev. 2020, 29, 200021. [Google Scholar] [CrossRef]
- Flament, T.; Bigot, A.; Chaigne, B.; Henique, H.; Diot, E.; Marchand-Adam, S. Pulmonary manifestations of Sjögren’s syndrome. Eur. Respir. Rev. 2016, 25, 110–123. [Google Scholar] [CrossRef]
- Narváez, J. Moving forward in Reumatoid Artrite-Associated Interstitial Lung Disease Screening. J. Clin. Med. 2024, 13, 5385. [Google Scholar] [CrossRef]
- Laria, A.; Lurati, A.M.; Zizzo, G.; Zaccara, E.; Mazzocchi, D.; Re, K.A.; Marrazza, M.; Faggioli, P.; Mazzone, A. Interstitial Lung Disease in Rheumatoid Arthritis: A Practical Review. Front. Med. 2022, 9, 837133. [Google Scholar] [CrossRef]
- Ryerson, C.J.; Urbania, T.H.; Richeldi, L.; Mooney, J.J.; Lee, J.S.; Jones, K.D.; Elicker, B.M.; Koth, L.L.; King, T.E., Jr.; Wolters, P.J.; et al. Prevalence and prognosis of unclassifiable interstitial lung disease. Eur. Respir. J. 2013, 42, 750–757. [Google Scholar] [CrossRef]
- Sebastiani, M.; Vacchi, C.; Cassone, G.; Manfredi, A. Diagnosis, Clinical Features and Management of Interstitial Lung Diseases in Rheumatic Disorders: Still a Long Journey. J. Clin. Med. 2022, 11, 410. [Google Scholar] [CrossRef] [PubMed]
- Shaw, M.; Collins, B.F.; Ho, L.A.; Raghu, G. Rheumatoid arthritis-associated lung disease. Eur. Respir. Rev. 2015, 24, 1–16. [Google Scholar] [CrossRef]
- Richter, P.; Cordoneanu, A.; Dima, N.; Bratoiu, I.; Rezus, C.; Burlui, A.M.; Costin, D.; Macovei, L.A.; Rezus, E. Interstitial Lung Disease in Systemic Lupus Erythematosus and Systemic Sclerosis: How Can We Manage the Challenge? Int. J. Mol. Sci. 2023, 24, 9388. [Google Scholar] [CrossRef]
- Didier, K.; Bolko, L.; Giusti, D.; Toquet, S.; Robbins, A.; Antonicelli, F.; Servettaz, A. Autoantibodies Associated With Connective Tissue Diseases: What Meaning for Clinicians? Front. Immunol. 2018, 9, 541. [Google Scholar] [CrossRef]
- Shin, J.I.; Lee, K.H.; Park, S.; Yang, J.W.; Kim, H.J.; Song, K.; Lee, S.; Na, H.; Jang, Y.J.; Nam, J.Y.; et al. Systemic Lupus Erythematosus and Lung Involvement: A Comprehensive Review. J. Clin. Med. 2022, 11, 6714. [Google Scholar] [CrossRef]
- Hilberg, O.; Hoffmann-Vold, A.M.; Smith, V.; Bouros, D.; Kilpeläinen, M.; Guiot, J.; Morais, A.; Clemente, S.; Daniil, Z.; Papakosta, D.; et al. Epidemiology of interstitial lung diseases and their progressive-fibrosing behaviour in six European countries. ERJ Open Res. 2022, 8, 00597–02021. [Google Scholar] [CrossRef]
- Cottin, V.; Hirani, N.A.; Hotchkin, D.L.; Nambiar, A.M.; Ogura, T.; Otaola, M.; Skowasch, D.; Park, J.S.; Poonyagariyagorn, H.K.; Wuyts, W.; et al. Presentation, diagnosis and clinical course of the spectrum of progressive-fibrosing interstitial lung diseases. Eur. Respir. Rev. 2018, 27, 180076. [Google Scholar] [CrossRef]
- Distler, O.; Highland, K.B.; Gahlemann, M.; Azuma, A.; Fischer, A.; Mayes, M.D.; Raghu, G.; Sauter, W.; Girard, M.; Alves, M.; et al. SENSCIS Trial Investigators. Nintedanib for Systemic Sclerosis-Associated Interstitial Lung Disease. N. Engl. J. Med. 2019, 380, 2518–2528. [Google Scholar] [CrossRef]
- Kolb, M.; Vašáková, M. The natural history of progressive fibrosing interstitial lung diseases. Respir. Res. 2019, 20, 57. [Google Scholar] [CrossRef]
- Cottin, V.; Brown, K.K. Systemic sclerosis-associated interstitial lung disease (SSc-ILD). Breath Res. 2019, 20, 13. [Google Scholar] [CrossRef]
- Fairley, J.L.; Goh, N.S.L.; Nikpour, M. Systemic sclerosis-associated interstitial lung disease: Diagnostic approaches and challenges. Rev. Colomb. Reumatol. 2024, 31, S15–S25. [Google Scholar] [CrossRef]
- Khanna, D.; Tashkin, D.P.; Denton, C.P.; Renzoni, E.A.; Desai, S.R.; Varga, J. Etiology, Risk Factors, and Biomarkers in Systemic Sclerosis with Interstitial Lung Disease. Am. J. Respir. Crit. Care Med. 2020, 201, 650–660. [Google Scholar] [CrossRef]
- Wu, W.; Jordan, S.; Graf, N.; de Oliveira Pena, J.; Curram, J.; Allanore, Y.; Matucci-Cerinic, M.; Pope, J.E.; Denton, C.P.; Khanna, D.; et al. EUSTAR Collaborators. Progressive skin fibrosis is associated with a decline in lung function and worse survival in patients with diffuse cutaneous systemic sclerosis in the European Scleroderma Trials and Research (EUSTAR) cohort. Ann. Rheum. Dis. 2019, 78, 648–656. [Google Scholar] [CrossRef]
- Boonstra, M.; Bakker, J.A.; Grummels, A.; Ninaber, M.K.; Ajmone Marsan, N.; Wortel, C.M.; Huizinga, T.W.J.; Jordan, S.; Hoffman-Vold, A.M.; Distler, O.; et al. Association of Anti-Topoisomerase I Antibodies of the IgM Isotype With Disease Progression in Anti-Topoisomerase I-Positive Systemic Sclerosis. Arthritis Rheumatol. 2020, 72, 1897–1904. [Google Scholar] [CrossRef]
- Hoffmann-Vold, A.M.; Midtvedt, Ø.; Tennøe, A.H.; Garen, T.; Lund, M.B.; Aaløkken, T.M.; Andreassen, A.K.; Elhage, F.; Brunborg, C.; Taraldsrud, E.; et al. Cardiopulmonary Disease Development in Anti-RNA Polymerase III-positive Systemic Sclerosis: Comparative Analyses from an Unselected, Prospective Patient Cohort. J. Rheumatol. 2017, 44, 459–465. [Google Scholar] [CrossRef]
- Volkmann, E.R.; Tashkin, D.P.; Leng, M.; Kim, G.H.J.; Goldin, J.; Roth, M.D. Association of Symptoms of Gastroesophageal Reflux, Esophageal Dilation, and Progression of Systemic Sclerosis-Related Interstitial Lung Disease. Arthritis Care Res. 2023, 75, 1690–1697. [Google Scholar] [CrossRef]
- Goh, N.S.; Desai, S.R.; Veeraraghavan, S.; Hansell, D.M.; Copley, S.J.; Maher, T.M.; Corte, T.J.; Sander, C.R.; Ratoff, J.; Devaraj, A.; et al. Interstitial lung disease in systemic sclerosis: A simple staging system. Am. J. Respir. Crit. Care Med. 2008, 177, 1248–1254. [Google Scholar] [CrossRef]
- Nihtyanova, S.I.; Schreiber, B.E.; Ong, V.H.; Rosenberg, D.; Moinzadeh, P.; Coghlan, J.G.; Wells, A.U.; Denton, C.P. Prediction of pulmonary complications and long-term survival in systemic sclerosis. Arthritis Rheumatol. 2014, 66, 1625–1635. [Google Scholar] [CrossRef]
- Wangkaew, S.; Euathrongchit, J.; Wattanawittawas, P.; Kasitanon, N. Correlation of delta high-resolution computed tomography (HRCT) score with delta clinical variables in early systemic sclerosis (SSc) patients. Quant. Imaging Med. Surg. 2016, 6, 381–390. [Google Scholar] [CrossRef]
- Valerio Marzano, A.; Morabito, A.; Berti, E.; Caputo, R. Elevated circulating CA 15.3 levels in a subset of systemic sclerosis with severe lung involvement. Arch. Dermatol. 1998, 134, 645. [Google Scholar] [CrossRef]
- Hoffmann-Vold, A.M.; Tennøe, A.H.; Garen, T.; Midtvedt, Ø.; Abraityte, A.; Aaløkken, T.M.; Lund, M.B.; Brunborg, C.; Aukrust, P.; Ueland, T.; et al. High Level of Chemokine CCL18 Is Associated With Pulmonary Function Deterioration, Lung Fibrosis Progression, and Reduced Survival in Systemic Sclerosis. Chest 2016, 150, 299–306. [Google Scholar] [CrossRef]
- Zanatta, E.; Cocconcelli, E.; Castelli, G.; Giraudo, C.; Fraia, A.S.; De Zorzi, E.; Gatto, M.; Ienna, L.; Treppo, E.; Malandrino, D.; et al. Interstitial lung disease with and without progressive fibrosing phenotype in patients with idiopathic inflammatory myopathies: Data from a large multicentric cohort. RMD Open 2023, 9, e003121. [Google Scholar] [CrossRef]
- Ferreira, J.P.; Almeida, I.; Marinho, A.; Cerveira, C.; Vasconcelos, C. Anti-ro52 antibodies and interstitial lung disease in connective tissue diseases excluding scleroderma. ISRN Rheumatol. 2012, 2012, 415272. [Google Scholar] [CrossRef]
- Lin, W.; Xin, Z.; Zhang, J.; Liu, N.; Ren, X.; Liu, M.; Su, Y.; Liu, Y.; Yang, L.; Guo, S.; et al. Interstitial lung disease in Primary Sjögren’s syndrome. BMC Pulm. Med. 2022, 22, 73. [Google Scholar] [CrossRef]
- Escolà-Vergé, L.; Pinal-Fernandez, I.; Fernandez-Codina, A.; Callejas-Moraga, E.L.; Espinosa, J.; Marin, A.; Labrador-Horrillo, M.; Selva-O’Callaghan, A. Mixed Connective Tissue Disease and Epitope Spreading: An Historical Cohort Study. J. Clin. Rheumatol. 2017, 23, 155–159. [Google Scholar] [CrossRef]
- Maddison, P.J. Overlap syndromes and mixed connective tissue disease. Curr. Opin. Rheumatol. 1991, 3, 995–1000. [Google Scholar] [CrossRef]
- Kozuka, T.; Johkoh, T.; Honda, O.; Mihara, N.; Koyama, M.; Tomiyama, N.; Hamada, S.; Nakamura, H.; Ichikado, K. Pulmonary involvement in mixed connective tissue disease: High-resolution CT findings in 41 patients. J. Thorac. Imaging 2001, 16, 94–98. [Google Scholar] [CrossRef]
- Zamora-Legoff, J.A.; Krause, M.L.; Crowson, C.S.; Ryu, J.H.; Matteson, E.L. Patterns of interstitial lung disease and mortality in rheumatoid arthritis. Rheumatology 2017, 56, 344–350. [Google Scholar] [CrossRef]
- Mena-Vázquez, N.; Rojas-Gimenez, M.; Romero-Barco, C.M.; Manrique-Arija, S.; Francisco, E.; Aguilar-Hurtado, M.C.; Añón-Oñate, I.; Pérez-Albaladejo, L.; Ortega-Castro, R.; Godoy-Navarrete, F.J.; et al. Predictors of Progression and Mortality in Patients with Prevalent Rheumatoid Arthritis and Interstitial Lung Disease: A Prospective Cohort Study. J. Clin. Med. 2021, 10, 874. [Google Scholar] [CrossRef]
- Zamora-Legoff, J.A.; Krause, M.L.; Crowson, C.S.; Ryu, J.H.; Matteson, E.L. Progressive decline of lung function in rheumatoid arthritis-associated interstitial lung disease. Rheumatol. Arthritis 2017, 69, 542–549. [Google Scholar] [CrossRef]
- Wang, H.F.; Wang, Y.Y.; Li, Z.Y.; He, P.J.; Liu, S.; Li, Q.S. The prevalence and risk factors of rheumatoid arthritis-associated interstitial lung disease: A systematic review and meta-analysis. Ann. Med. 2024, 56, 2332406. [Google Scholar] [CrossRef]
- Sparks, J.A.; He, X.; Huang, J.; Fletcher, E.A.; Zaccardelli, A.; Friedlander, H.M.; Gill, R.R.; Hatabu, H.; Nishino, M.; Murphy, D.J.; et al. Rheumatoid Arthritis Disease Activity Predicting Incident Clinically Apparent Rheumatoid Arthritis-Associated Interstitial Lung Disease: A Prospective Cohort Study. Arthritis Rheumatol. 2019, 71, 1472–1482. [Google Scholar] [CrossRef]
- Kim, H.C.; Choi, K.H.; Jacob, J.; Song, J.W. Prognostic role of blood KL-6 in rheumatoid arthritis-associated interstitial lung disease. PLoS ONE 2020, 15, e0229997. [Google Scholar] [CrossRef] [PubMed]
- Koduri, G.M.; Podlasek, A.; Pattapola, S.; Zhang, J.; Laila, D.; Nandagudi, A.; Dubey, S.; Kelly, C. Four-factor risk score for the prediction of interstitial lung disease in rheumatoid arthritis. Rheumatol. Int. 2023, 43, 1515–1523. [Google Scholar] [CrossRef]
- Enomoto, N.; Egashira, R.; Tabata, K.; Hashisako, M.; Kitani, M.; Waseda, Y.; Ishizuka, T.; Watanabe, S.; Kasahara, K.; Izumi, S.; et al. Analysis of systemic lupus erythematosus-related interstitial pneumonia: A retrospective multicentre study. Sci. Rep. 2019, 9, 7355. [Google Scholar] [CrossRef]
- Molina-Molina, M.; Castellví, I.; Valenzuela, C.; Ramirez, J.; Rodríguez Portal, J.A.; Franquet, T.; Narváez, J. Management of progressive pulmonary fibrosis associated with connective tissue disease. Expert Rev. Respir. Med. 2022, 16, 765–774. [Google Scholar] [CrossRef]
- Martín-López, M.; Carreira, P.E. The Impact of Progressive Pulmonary Fibrosis in Systemic Sclerosis-Associated Interstitial Lung Disease. J. Clin. Med. 2023, 12, 6680. [Google Scholar] [CrossRef]
- Cottin, V.; Wollin, L.; Fischer, A.; Quaresma, M.; Stowasser, S.; Harari, S. Fibrosing interstitial lung diseases: Knowns and unknowns. Eur. Respir. Rev. 2019, 28, 180100. [Google Scholar] [CrossRef]
- Lia, Y.; Fana, Y.; Wanga, Y.; Yanga, S.; Dua, X.; Yea, Q. Phenotypic clusters and survival analyses in interstitial pneumonia with myositis-specific autoantibodies. Sarcoidosis Vasc. Diffuse Lung Dis. 2022, 38, e2021047. [Google Scholar] [CrossRef]
- Hallowell, R.W.; Danoff, S.K. Diagnosis and Management of Myositis-Associated Lung Disease. Chest 2023, 163, 1476–1491. [Google Scholar] [CrossRef]
- Hannah, J.R.; Lawrence, A.; Martinovic, J.; Naqvi, M.; Chua, F.; Kouranos, V.; Ali, S.S.; Stock, C.; Owens, C.; Devaraj, A.; et al. Antibody predictors of mortality and lung function trends in myositis spectrum interstitial lung disease. Rheumatology 2023, 1, kead638. [Google Scholar] [CrossRef]
- Mecoli, C.A.; Igusa, T.; Chen, M.; Wang, X.; Albayda, J.; Paik, J.J.; Tiniakou, E.; Adler, B.; Richardson, C.; Kelly, W.; et al. Subsets of Idiopathic Inflammatory Myositis Enriched for Contemporaneous Cancer Relative to the General Population. Arthritis Rheumatol. 2023, 75, 620–629. [Google Scholar] [CrossRef]
- Nuno-Nuno, L.; Joven, B.E.; Carreira, P.E.; Maldonado-Romero, V.; Larena-Grijalba, C.; Cubas, I.L.; Tomero, E.G.; Barbadillo-Mateos, M.C.; De la Peña Lefebvre, P.G.; Ruiz-Gutiérrez, L.; et al. Mortality and prognostic factors in idiopathic inflammatory myositis: A retrospective analysis of a large multicenter cohort of Spain. Rheumatol. Int. 2017, 37, 1853–1861. [Google Scholar] [CrossRef] [PubMed]
- Kardes, S.; Gupta, L.; Aggarwal, R. Cancer and myositis: Who, when, and how to screen. Best Pract. Res. Clin. Rheumatol. 2022, 36, 101771. [Google Scholar] [CrossRef]
- Oldroyd, A.G.S.; Callen, J.P.; Chinoy, H.; Chung, L.; Fiorentino, D.; Gordon, P.; Machado, P.M.; McHugh, N.; Selva-O’Callaghan, A.; Schmidt, J.; et al. International Guideline for Idiopathic Inflammatory Myopathy-Associated Cancer Screening: An International Myositis Assessment and Clinical Studies Group (IMACS) initiative. Nat. Rev. Rheumatol. 2023, 19, 805–817. [Google Scholar] [CrossRef] [PubMed] [PubMed Central]
- Manfredi, A.; Vacchi, C.; DellaCasa, G.; Cerri, S.; Cassone, G.; Di Cecco, G.; Luppi, F.; Salvarani, C.; Sebastiani, M. Fibrosing interstitial lung disease in primary Sjogren syndrome. Jt. Bone Spine 2021, 88, 105237. [Google Scholar] [CrossRef]
- Chen, Y.H.; Lee, T.J.; Hsieh, H.J.; Hsieh, S.C.; Wang, H.C.; Chang, Y.C.; Yu, C.J.; Chien, J.Y. Clinical outcomes and risk factors of progressive pulmonary fibrosis in primary Sjögren’s syndrome-associated interstitial lung disease. BMC Pulm. Med. 2023, 23, 268. [Google Scholar] [CrossRef]
- Pugashetti, J.V.; Adegunsoye, A.; Wu, Z.; Lee, C.T.; Srikrishnan, A.; Ghodrati, S.; Vo, V.; Renzoni, E.A.; Wells, A.U.; Garcia, C.K.; et al. Validation of proposed criteria for progressive pulmonary fibrosis. Am. J. Respir. Crit. Care Med. 2023, 207, 69–76. [Google Scholar] [CrossRef] [PubMed] [PubMed Central]
- D’Agnano, V.; Mariniello, D.F.; Ruotolo, M.; Quarcio, G.; Moriello, A.; Conte, S.; Sorrentino, A.; Sanduzzi Zamparelli, S.; Bianco, A.; Perrotta, F. Targeting Progression in Pulmonary Fibrosis: An Overview of Underlying Mechanisms, Molecular Biomarkers, and Therapeutic Intervention. Life 2024, 14, 229. [Google Scholar] [CrossRef] [PubMed] [PubMed Central]
- Nambiar, A.M.; Walker, C.M.; Sparks, J.A. Monitoring and management of fibrosing interstitial lung diseases: A narrative review for practicing clinicians. Ther. Adv. Respir. Dis. 2021, 15, 17534666211039771. [Google Scholar] [CrossRef]





| Type of SARDs | Risk Factors for SARD-ILD | References |
|---|---|---|
| SSc | Anti-SCL-70 and speckled antinuclear antibodies positivity | [22] |
| Male gender | [23] | |
| African-American race | [24,25] | |
| Diffuse form of SSc | [24,25] | |
| Recently discovered disease (in the first 5–7 years) | [22] | |
| Increased values of acute phase reactants | [22,23] | |
| Anti-TRIM21 positivity | [26] | |
| IIMs | Advanced age at diagnosis | [27] |
| Arthritis/arthralgia | [27,28] | |
| Fever, arthritis, Raynaud’s phenomenon, skin manifestations of the “mechanic’s hands” type | [27,29] | |
| Elevated levels of ESR and CRP | [27,30] | |
| ANA positivity | [31] | |
| Anti-Jo-1 positivity | [30] | |
| Anti-MDA5 positivity | [30,32] | |
| SjS | Male gender | [33] |
| Smoking | [33] | |
| Older age (over 65 years) | [33] | |
| Long course of the disease | [33] | |
| Raynaud syndrome | [34] | |
| Increased values of ESR, CRP, lactate dehydrogenase | [35] | |
| Lymphopenia | [34] | |
| ANA and anti-Ro52/SSA positivity | [36,37] | |
| Anti-TRIM21 positivity | [26] | |
| MCTD | Dysphagia | [38] |
| Raynaud’s phenomenon | [39] | |
| Elevated C-reactive protein | [38,40] | |
| Anti-Ro52 and anti-Sm positivity | [38,41] | |
| Long life with MCTD | [41] | |
| Old age | [41] | |
| Male gender | [40,42] | |
| Anti-RNP elevated titer | [40,42] | |
| RA | Male gender | [43,44,45] |
| Aged over 65 years | [23,44] | |
| Old smokers (>10 pack-years) | [43,44,45] | |
| Rheumatoid nodules and erosive joint damage presence | [36,37] | |
| High activity of RA | [43,46,47,48] | |
| Functional impairment | [49] | |
| Long duration of the disease | [46] | |
| Anti-citrullinated peptide antibodies (anti-CCP) positivity | [50,51,52,53] | |
| Increased titers of rheumatoid factor (>100 IU/mL) | [50,52,53] | |
| Presence of mutations in the MUC5B gene | [54] | |
| Anti-TRIM21 positivity | [26] | |
| SLE | Advanced age (over 50 years) | [41,55] |
| Coexistence of another autoimmune disease (such as SjS or SSc) | [41] | |
| Duration of autoimmune disease (an average of 7.7 years between the onset of SLE and ILD) | [41] | |
| SLEDAI higher | [41] | |
| Association with other clinical manifestations such as Raynaud’s phenomenon or sclerodactyly in an overlap syndrome | [41,56] | |
| Low albumin levels | [56] | |
| Increased levels of acute-phase reactants | [56] | |
| Low level of complement | [56] | |
| Elevated levels of double-stranded DNA (dsDNA) antibodies | [56] | |
| Anti-La, anti-Scl-70 and anti-U1RNP positivity | [56] |
| ILD | Findings HRCT | Findings Pathological | ||
|---|---|---|---|---|
| Characteristics | Distribution | Additional Features | Microscopic Features | |
| NSIP [61,62,63,64] | “Ground glass” opacities, thickening of the alveolar septa. | Diffuse, predominantly in the lower lobes. | Reduction of lung volume, preservation of lung architecture, absence of hyaline membranes, and traction bronchiectasis may occur. | Lesions of alveolitis and fibrosis are uniform in age and diffusely affect the alveolar septa. Fibroblastic foci are absent, and lung architecture remains preserved. Hyaline membranes and granulomas are not typically present [65]. |
| UIP [66] | Reticular, retractile-type opacities. | Predominantly in the lower lobes and subpleural regions. | Traction bronchiectasis and subpleural microcysts (“honeycombing”). | The pattern features alveolitis, fibrosis, fibroblastic foci, and honeycomb changes, alternating with normal lung areas. Subpleural and basal regions are the most affected. Fibrosis exceeds inflammation, with smooth muscle proliferation and type II alveolocyte hyperplasia, absent hyaline membranes [66]. |
| COP [67] | Multiple pulmonary consolidations, usually bilateral; solitary consolidations. | Subpleural and in the lower lung fields. | “Ground glass (GGO)” lesions (frequent), annular opacities (less frequent), diffuse–infiltrative forms, minimal pleural effusion, migratory opacities. | COP is marked by granulation tissue within alveolar ducts and alveoli, with mononuclear inflammation and foamy macrophages. Fibrotic foci, called Masson corpuscles, appear as polyp-like structures. The lesions are homogeneous and maintain the overall lung architecture [67]. |
| DIP [68,69] | “Ground glass” opacities. | Bilateral, predominantly in the lower lung fields, peripherally; may also be localized in the upper and middle lungs. | Thickening of intralobular septae, especially subpleural and basal (60–80% of cases), traction bronchiectasis, or honeycombing are rarer (25–30% of cases). | DIP typically features pigmented macrophages in alveoli, type II pneumocyte hyperplasia, and mild interstitial fibrosis. Lesions are diffuse and homogeneous, unlike UIP, which shows a mottled pattern with less uniformity [70]. |
| LIP [71] | Reticular and nodular opacities. | Bilateral basal. | ”Ground glass” lesions as the disease progresses, thin-walled cysts, 1–3 cm in diameter (60–80% of cases). | LIP features diffuse lymphoid hyperplasia affecting the lung interstitium, with lymphocytes, plasma cells, histiocytes, and reactive follicles in interalveolar septa. Advanced stages may show fibrosis and honeycombing [72]. |
| AIP [73,74] | Areas of alveolar consolidation or “ground glass” opacities. | These changes are never subpleural or centrally localized. | The extent of the affected area correlates with the duration of the disease. Initially, ”ground glass” opacities are bilateral in focal areas and alternate with areas of unaffected lobules. | AIP, or diffuse alveolar damage, progresses rapidly through three phases: (1) the acute exudative phase (edema, hyaline membranes, inflammation), (2) the subacute proliferative phase (fibroblast proliferation, type II pneumocyte hyperplasia), and (3) chronic fibrotic phase (collagen deposits, occasional intraluminal thrombi) [75]. |
| DAH [76] | Bilateral ground glass opacities associated with “crazy cobblestone pattern”. | Subpleural sparing is often a useful diagnostic feature. | In the subacute HRCT phase, fine diffuse nodular densities will appear, and in the later phase, there may be evidence of thickening of the interlobular septum due to intralymphatic accumulation of hemosiderin. | Diffuse intraalveolar blood admixed with hemosiderin-laden macrophages. Organizing fibroblastic tissue may also be present. In the case of capillaritis, neutrophils are seen within alveolar septa, resulting in vascular necrosis. Hyaline membranes may also be present [77]. |
| Type of SARD-ILD | HRCT Features | Axial HRCT Images in Patients with SARD-ILD | Description of HRCT Images in Patients with SARD-ILD |
|---|---|---|---|
| SSc-ILD | NSIP, UIP with straight-edge sign and/or “four corners” sign. | ![]() | NSIP, which is the most common appearance in patients with SSc-ILD, is characterized by reticular opacities arranged in bands that run parallel to the lung’s subpleural contour, with a tendency to avoid the subpleural area. |
| IIM-ILD | NSIP or OP. | ![]() | The appearance of OP is frequently encountered in IIM-ILD patients. It is characterized by ground glass areas alternating with areas of condensation, often with a perilobular distribution. OP can overlap with NSIP, leading to exacerbations of ILD, or it may present as the initial pattern. |
| SjS-ILD | NSIP; LIP with diffuse interstitial and peribronchiolar infiltration of lymphoplasma cells; OP. | ![]() | The appearance of LIP, commonly seen in patients with SjS, can be associated with ground glass lesions, nodules, septal thickenings, and cysts. The middle and lower lung fields are most frequently affected. |
| RA-ILD | UIP; NSIP; airway disease with obliterative and follicular bronchiolitis; rheumatoid nodules. | ![]() | UIP, specific to RA-ILD, is characterized by traction bronchiectasis, which may present as subpleural fibrotic cysts with a “honeycomb” appearance, overlapping in multiple layers. UIP often represents the final stage in the progression of most connective tissue diseases and is associated with the most severe prognosis. |
| SLE-ILD | NSIP, AIP, and DAH. | ![]() | The appearance of DAH is characterized by areas of ground glass, which can evolve into consolidations due to intralobular blood accumulation. DAH is a life-threatening complication in patients with SLE-ILD. |
| Type of SARDs | Risk Predictors for PPF | References |
|---|---|---|
| SSc-ILD | older age at the onset of SSc | [169,170] |
| male gender | [171] | |
| diffuse cutaneous systemic sclerosis | [172] | |
| anti-Scl-70 positivity | [171,173] | |
| anti-RNAP3 | [174] | |
| presence of GERD and esophageal structural changes | [175] | |
| high severity of ILD at the time of diagnosis more than 20% extension of fibrosis on HRCT | [176] | |
| reduced DLco levels | [176] | |
| reduced FVC levels | [177] | |
| decreased oxygen saturation | [178] | |
| elevated serum levels of some structural biomarkers (CA15-3) | [179] | |
| elevated serum levels of chemokines (CCL-18) | [180] | |
| IIM-ILD | heliotropic rash | [181] |
| anti-MDA5 positivity | [181] | |
| anti-Ro 52 positivity | [182] | |
| SjS-ILD | male gender | [42,183] |
| reticular pattern on HRCT | [42,183] | |
| non-sicca phenotype | [42,183] | |
| UIP pattern | [42,183] | |
| MCTD-ILD | advanced age | [64] |
| digital ulcers | [184] | |
| anti-Ro52 positivity | [185] | |
| NSIP pattern | [186] | |
| RA-ILD | older age | [187] |
| male gender | [187] | |
| smoking status | [188] | |
| UIP pattern or greater extension of ILD | [189] | |
| moderate and high values (≥3.2) of DAS28 | [190,191] | |
| increased blood levels of KL-6 | [192] | |
| increased titers of rheumatoid factor or anti-CCP | [193] | |
| low initial values of FVC and DLco | [187] | |
| rapid decrease of values of FVC and DLco over 6 months | [187] | |
| SLE-ILD | current smoking status | [194] |
| increased serum levels of KL-6 | [194] | |
| projected extension of fibrosis | [194] | |
| NSIP plus OP patterns vs. NSIP pattern | [194] | |
| neuropsychiatric lupus | [194] | |
| thrombocytopenia | [194] | |
| other comorbidities of SLE | [194] | |
| Elevated anti-dsDNA titers | [194,195] | |
| Presence of overlapping syndromes | [160] |
Disclaimer/Publisher’s Note: The statements, opinions and data contained in all publications are solely those of the individual author(s) and contributor(s) and not of MDPI and/or the editor(s). MDPI and/or the editor(s) disclaim responsibility for any injury to people or property resulting from any ideas, methods, instructions or products referred to in the content. |
© 2024 by the authors. Licensee MDPI, Basel, Switzerland. This article is an open access article distributed under the terms and conditions of the Creative Commons Attribution (CC BY) license (https://creativecommons.org/licenses/by/4.0/).
Share and Cite
Biciusca, V.; Rosu, A.; Stan, S.I.; Cioboata, R.; Biciusca, T.; Balteanu, M.A.; Florescu, C.; Camen, G.C.; Cimpeanu, O.; Bumbea, A.M.; et al. A Practical Multidisciplinary Approach to Identifying Interstitial Lung Disease in Systemic Autoimmune Rheumatic Diseases: A Clinician’s Narrative Review. Diagnostics 2024, 14, 2674. https://doi.org/10.3390/diagnostics14232674
Biciusca V, Rosu A, Stan SI, Cioboata R, Biciusca T, Balteanu MA, Florescu C, Camen GC, Cimpeanu O, Bumbea AM, et al. A Practical Multidisciplinary Approach to Identifying Interstitial Lung Disease in Systemic Autoimmune Rheumatic Diseases: A Clinician’s Narrative Review. Diagnostics. 2024; 14(23):2674. https://doi.org/10.3390/diagnostics14232674
Chicago/Turabian StyleBiciusca, Viorel, Anca Rosu, Sorina Ionelia Stan, Ramona Cioboata, Teodora Biciusca, Mara Amalia Balteanu, Cristina Florescu, Georgiana Cristiana Camen, Ovidiu Cimpeanu, Ana Maria Bumbea, and et al. 2024. "A Practical Multidisciplinary Approach to Identifying Interstitial Lung Disease in Systemic Autoimmune Rheumatic Diseases: A Clinician’s Narrative Review" Diagnostics 14, no. 23: 2674. https://doi.org/10.3390/diagnostics14232674
APA StyleBiciusca, V., Rosu, A., Stan, S. I., Cioboata, R., Biciusca, T., Balteanu, M. A., Florescu, C., Camen, G. C., Cimpeanu, O., Bumbea, A. M., Boldeanu, M. V., & Banicioiu-Covei, S. (2024). A Practical Multidisciplinary Approach to Identifying Interstitial Lung Disease in Systemic Autoimmune Rheumatic Diseases: A Clinician’s Narrative Review. Diagnostics, 14(23), 2674. https://doi.org/10.3390/diagnostics14232674